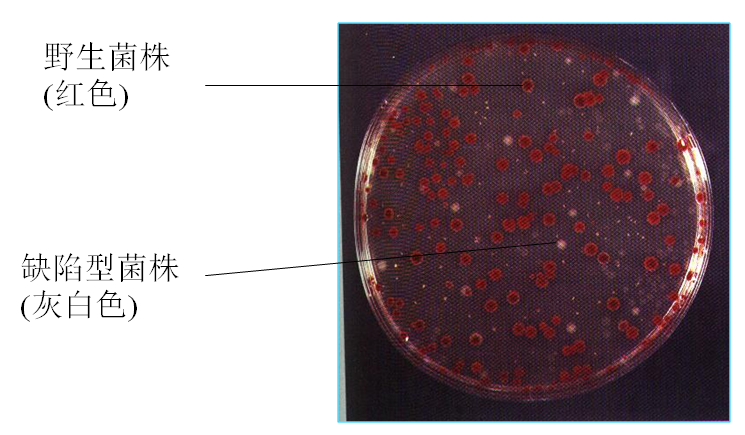

-
1 内容
-
2 练习
内容
基因突变

基因突变的定义:一个基因内部遗传结构或DNA序列的任何改变,包括一对或少数几对碱基的缺失、插入或置换,而导致的遗传变化称为基因突变(gene mutation),其发生变化的范围很小,所以又称点突变(point mutati on)或狭义的突变。广义的突变又称染色体畸变(chromosomal aberration),包括大段染色体的缺失、重复、倒位。
基因突变的特点:
◆ 不对应性:引起突变的因素和突变出的性状没有对应关系。
◆ 自发性:自然状况下也可发生。
◆ 稀有性:10-6 —10-9间。
◆ 独立性:突变的发生一般是独立的。
◆ 诱变性:采用某种方法、药品可使突变率增加。
◆ 稳定性:新产生的性状是稳定的、可遗传的。
◆ 可逆性:既可发生正向突变,也可发生回复突变。
◆ 多方向性:复等位基因
基因突变的类型
按发生方式:自发、诱发;
按突变表型:营养缺陷型、抗药性突变型、条件致死突变型、形态突变型;
按遗传物质的结构改变:染色体畸变、基因突变;
按碱基变化与遗传信息的改变:同义突变、错义突变、无义突变、移码突变。
基因突变自发性和不对应性的证明实验:
Luria的变量实验、

Newcombe的涂布实验、


Lederberg等的影印平板实验

基因突变的机制
◆ 诱变的机制
碱基的置换


移码突变
诱变剂使DNA分子中的一个或少数几个核苷酸的增加或缺失,从而使后面的全部遗传密码发生转录和转译错误。

染色体畸变
某些强烈的理化因子,如电离辐射(X射线等)和烷化剂、亚硝酸等,除了能引起基因的点突变以外,还会引起DNA分子的大损伤---染色体畸变,既包括染色体结构上的缺失、重复、倒位、易位,也包括染色体数目的变化。
◆ 自发突变机制
(1)背景辐射、环境因素
(2)微生物自身有害物质:微生物体内的一种代谢产物(过氧化氢)。
(3)DNA复制中碱基配对错误引起
(4)转座因子引起的插入或缺失所诱导的自发突变
紫外线对DNA损伤及修复
紫外线对DNA损伤:嘧啶对紫外线比嘌呤敏感得多,其光化学反应产物主要是嘧啶二聚体和水合物,相邻嘧啶形成二聚体后,造成局部DNA分子无法配对,从而引起微生物的死亡或突变。
紫外线对DNA损伤的修复:光复活作用、切除修复。

案例
细菌原生质体融合
原核微生物基因重组主要可通过转化、转导、接合等途径,但有些微生物不适于采用这些途径,从而使育种工作受到一定的限制。
原生质体融合的优点:
(1)克服种属间杂交的“不育性”,可以进行远缘杂交。由于用酶解除去细胞壁,因此,即使相同接合型的真菌或不同种属间的微生物,皆可发生原生质体融合,产生重组子。
(2)基因重组频率高,重组类型多。原生质体融合时,由于聚乙二醇(PEG)起促融合的作用,使细胞相互聚集,可以提高基因重组率。原生质体融合后,两个亲株的整套基因组(包括细胞核、细胞质)相互接触,发生多位点的交换,从而产生各种各样的基因组合,获得多种类型的重组子。
(3)可将由其他育种方法获得的优良性状,经原生质体融合而组合到一个菌株中。
(4)存在着两个以上亲株同时参与融合,可形成多种性状的融合子。
原生质体的制备:
1)培养枯草芽孢杆菌:取亲本菌株T4412、TT2新鲜斜面分别接一环到装有液体完全培养基(CM)的试管中,36℃振荡培养14h,各取1mL菌液转接入装有20mL液体完全培养基的250mL锥形瓶中,36℃振荡培养3h,使细胞生长进入对数前期,各加入25u/mL青霉素,使其终浓度为0.3u/mL,继续振荡培养2h。
2)收集细胞:各取菌液10mL,4000r/min离心10min,弃上清液,将菌体悬浮于磷酸缓冲液中,离心。如此洗涤两次,将菌体悬浮10mLSMM中,每mL约含108~109活菌为宜。
3)总菌数测定:各取菌液0.5mL,用生理盐水稀释,取10-5、10-6、10-7各1mL(每稀释度作两个平板)、倾注完全培养基,36℃培养24h后计数。此为未经酶处理的总菌数。
4)脱壁:二株亲本菌株各取5mL菌悬液,加入5mL溶菌酶溶液,溶菌酶浓度为100ug/mL,混匀后于36℃水浴保温处理30min,定时取样,镜检观察原生质体形成情况,当95%以上细胞变成球状原生质体时,用4000r/min离心10min,弃上清液,用高渗缓冲液洗涤除酶,然后将原生质体悬浮于5mL高渗缓冲液中。立即进行剩余菌数的测定。
5)剩余菌数测定:取0.5mL上述原生质体悬液,用无菌水稀释,使原生质体裂解死亡,取10-2、10-3、10-4稀释液各0.1mL,涂布于完全培养基平板上,36℃培养24~48h,生长出的菌落应是未被酶裂解的剩余细胞。
计算酶处理后剩余细胞数,并分别计算二亲株的原生质体形成率。
原生质体形成率=未经酶处理的总菌数一酶处理后剩余细胞数
原生质体再生:用双层培养法,先倒再生补充基本固体培养基(SMR)作底层,取0.5mL原生质体悬液,用SMM作适当稀释,取10-3、10-4、10-5稀释液各1mL,加入底层平板培养基的中央,再倒入上层再生补充半固体培养基混匀,36℃培养48h。分别计算二亲株的原生质体的再生率,并计算其平均数。
原生质体融合:取两个亲本的原生质体悬液各1mL混合,放置5min后,2500r/min离心10min,弃上清液。于沉淀中加入0.2mLSMM溶液混匀,再加入1.8mLPEG溶液,轻轻摇匀,置36℃水浴保温处理2min,2500r/min离心10min,收集菌体,将沉淀充分悬浮于2mLSMM液中。
检出融合子:取0.5mL融合液,用SMM液作适当稀释,取0.1mL菌液与灭菌并冷却至50℃的再生补充基本培养基软琼脂中混匀,迅速倾入底层为再生补充基本培养基的平板上,36℃培养2d,捡出融合子,转接传代,并进行计数,计算融合率。
融合子的筛选:挑选遗传标记稳定的融合子,凡是在再生补充基本培养基平板上长出的菌落,初步认为是融合子,可接入到酪蛋白培养基平板上,再挑选蛋白酶活性高于亲本的融合子。由于原生质体融合后会出现两种情况:一种是真正的融合,即产生杂核二倍体或单倍重组体,另一种只发生质配,而无核配,形成异核体。两者都能在再生基本培养基平板上形成菌落,但前者稳定,而后者则不稳定。故在传代中将会分离为亲本类型。所以要获得真正融合子,必须进行几代的分离、纯化和选择。

